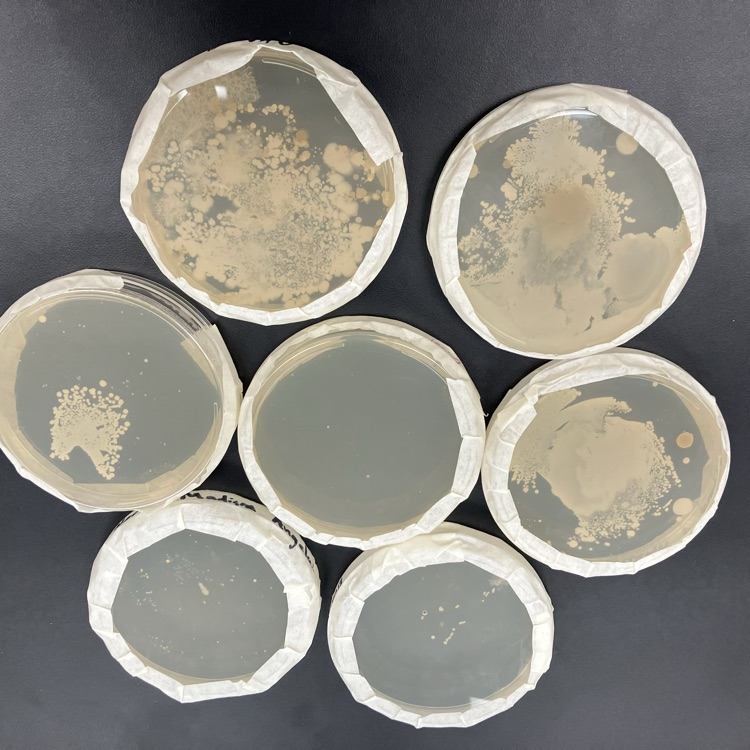
bacteria

Tiger boys had another close one tonight! Edging out Rock Hills 57-55! Definitely not our best outing but fought till the end for the win.
Next chance to see the Tigers is Dec 30th at Valley Heights vs Superior Neb. in the 2nd round of the Holiday Showcase!
See you there!
WCES had a great Crazy Christmas day. The day included a Santa visit for Kindergarten, 1st, and 2nd grades, caroling on the courthouse lawn, a visit from the Grinch, hot cocoa, and multiple fun actitivies for the students. Thank you to the 6th grade students for developing and running the activities for the Kindergarten, 1st and 2nd grades. We hope everyone has a great Winter Break! (part 3)







WCES had a great Crazy Christmas day. The day included a Santa visit for Kindergarten, 1st, and 2nd grades, caroling on the courthouse lawn, a visit from the Grinch, hot cocoa, and multiple fun actitivies for the students. Thank you to the 6th grade students for developing and running the activities for the Kindergarten, 1st and 2nd grades. We hope everyone has a great Winter Break! (part 2)







WCES had a great Crazy Christmas day. The day included a Santa visit for Kindergarten, 1st, and 2nd grades, caroling on the courthouse lawn, a visit from the Grinch, hot cocoa, and multiple fun actitivies for the students. Thank you to the 6th grade students for developing and running the activities for the Kindergarten, 1st and 2nd grades. We hope everyone has a great Winter Break! (part 1)










The district office had a special visitor on Friday....and it WASN'T the man in red! Ms. O'Dea and Miss Elizabeth both received an onion from the Grinch. Merry Christmas!





Mrs. Baker's class finished their social studies by completing their state report. They researched, took notes, created a Google slideshow, and presented to their class.







Mrs. Baker's class finished social studies with completing their state reports. They researched, took notes, created their Google slides presentation, and presented to their class. (Set 1)







School will not be in session 12/20/25-1/5/26. Classes resume January 6, 2026.
No habrá clases desde el 20 de diciembre de 2025 hasta el 5 de enero de 2026. Las clases se reanudarán el 6 de enero de 2026.
No habrá clases desde el 20 de diciembre de 2025 hasta el 5 de enero de 2026. Las clases se reanudarán el 6 de enero de 2026.

Our little Tigers enjoyed a visit from 🎅 yesterday at preschool! Merry Christmas!


Last year’s yearbook is available NOW for $40, and this year’s can be preordered for the same price. Sale ends Friday!

Dale the book man delivered an early Christmas gift to the elementary library! Thank you so much, Dale!



Witt made a quality bookcase for his grandmother out of oak. He is also pictured with a neat walnut and ash cutting board. He worked hard to get these done before Christmas. Good job, Witt!


Joree made a well-built cubby hole organizer to take with her to college. She made it out of birch. These come in handy to add storage space to an area. Good job, Joree!

Students in Earth Science designed earthquake resistant structures to hold eggs during an earthquake. Testing took place today.





Students in Earth Science designed earthquake resistant buildings to hold an egg during an earthquake. Testing took place today.







Maggie built a nice nightstand out of beech wood. Her partner in crime pictured here helped her finish the nightstand before Christmas. Good job, Maggie, and thanks to Madison for the help as well !

Students in STEM designed boats to carry cargo. They tested them yesterday in class.


Students in Biology have investigated the presence of bacteria in our school by sampling different areas for bacteria and incubating them in Petri dishes. Some results were quite surprising!

Carter made a beautiful duck and goose call. The duck call is made out of cocobolo wood with a brass band. The goose call with the copper band turned out neat as well. He has made some quality game calls the last few months. Good job, Carter!


